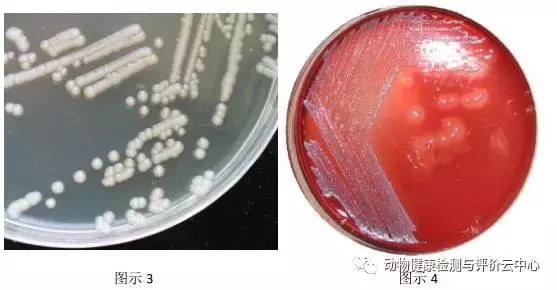
禽畜疾病实验室检测：常见细菌的分离鉴定（一）
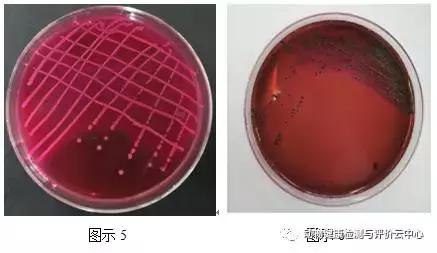
禽畜疾病实验室检测：常见细菌的分离鉴定（一）

镜检观察细菌形态是细菌分离试验的最后一关,要想鉴定细菌种类,各种常见细菌的分离培养方法、特性、形态的了解是前提。
常见细菌有很多,如:大肠杆菌、沙门氏菌、葡萄球菌、链球菌、弯曲杆菌、巴氏杆菌、弧菌、铜绿假单胞菌(绿脓杆菌)等,本次为给大家分享大肠杆菌、巴氏杆菌、铜绿假单胞菌三种常见菌的分离培养鉴定。
1、大肠杆菌
分离培养
以无菌操作的方法将待检病料,用接种环划线接种于麦康凯琼脂,或伊红美蓝培养基上37℃培养18-24小时观察菌落形态。大肠杆菌在麦康凯培养基上长出粉红色菌落(见图示1),并向培养基内部凹陷生长;在伊红美蓝培养基上长出紫黑色带金属光泽的单个菌落。
形态学镜检
取培养出的单个菌落,革兰氏染色后镜检,可见到革兰阴性、两端钝圆、长约1.5-3.0μm的短小杆菌,多单在,偶有2-3个菌体相连,无芽孢,无荚膜,大多有鞭毛,能运动(见图示2)。
培养特性
普通琼脂及血琼脂
形成圆形隆起,边缘整齐、光滑、湿润、半透明,近似灰白色、直径1.5-2mm的菌落(见图示3),有些菌株在血琼脂平板上呈β-溶血(图示4);
营养肉汤培养基
呈浑浊态,有少量白色沉淀产生,伴有轻微臭味;
麦康凯琼脂
形成粉红色或深红色、圆形隆起、光滑湿润、边缘整齐、直径为1.5-2.5mm小菌落(见图示5);
伊红美蓝琼脂
形成紫黑色、圆形、具有金属光泽、直径为2-3mm小菌落(见图示6);
SS琼脂
形成红色菌落,但其周围颜色稍淡。

大肠杆菌分离培养与形态学镜检
大肠杆菌在普通琼脂及血琼脂的培养
大肠杆菌在麦康凯琼脂和伊红美蓝琼脂的培养
2、巴氏杆菌
分离培养
对疑似感染巴氏杆菌的病例采取肝脏和胆囊病变组织器官,应先用刀片灼烧组织或渗出物,然后再用接种环或消毒棉签通过灼烧过的表面插入组织内取样,涂在全血(禽全血或者血清)培养基、麦康凯培养基和HE培养基上进行分离培养。
培养特性
多杀性巴氏杆菌生长需氧或兼性厌氧,最适生长温度为35~37 ℃,pH值为7.2~7.4。病菌在普通琼脂上可生长,但不旺盛,在血琼脂和葡萄糖淀粉琼脂上生长良好,适合于多杀性巴氏杆菌的初次分离。多杀性巴氏杆菌在血琼脂上菌落为淡灰白色、半透明、微隆起、表面光滑、边缘整齐的露珠样小菌落,菌落周围不溶血,不在麦康凯培养基上生长。
形态学镜检
如果血平板上有淡灰白色、半透明、微隆起、表面光滑、边缘整齐的露珠样小菌落,菌落周围不溶血,麦康凯培养基上无菌落生长,可以挑取此菌落进行染色镜检。革兰氏染色时为阴性,球杆状或短杆状,两端钝圆,以单个和成双排列为主。挑取血琼脂平板上可疑菌落,进行革兰氏染色,为革兰氏阴性细小的球杆状或短杆状菌,两端钝圆,近似椭圆形,大小为0.5-2.5mm×0.2-0.4mm,在培养物中呈圆形、卵圆形或杆状,单在,有时成双排列。病料涂片用瑞氏染色或美兰染色时,可见明显的两极着色。新分离的强毒菌株具有粘液性荚膜,但经培养后迅速消失。本菌无芽胞,无鞭毛。
3、铜绿假单胞菌(绿脓杆菌)
分离培养
无菌操作从病鸡的肝、脾、肾、心包液及肠粘膜分离细菌,分别划线于普通琼脂平板、血琼脂平板、SS平板、麦康凯琼脂平板,置37℃恒温箱培养24-72 h。
形态学镜检
挑取普通营养琼脂上光滑、微隆起、边缘整齐或波状的中等大小菌落培养基周围呈黄绿色,部分菌落可能呈现金属光泽,涂片染色镜检。
革兰阴性,直而细长的中等大小杆状细菌,菌体两端钝圆,直径(1.3-3.0μm)×(0.4-0.5μm),单个、成对或偶尔呈短链状存在,在肉汤培养基中可见到长丝状形态,能运动,不形成芽孢和荚膜(见图7)。

铜绿假单胞菌形态学镜检
培养特性
需氧或兼性厌氧,在普通培养基上易于生长。
普通肉汤
37℃培养18-24h,混浊生长,液面处有绿色色素。在液面的细菌生长旺盛,可形成一层很厚的菌膜,可见到稍清亮的淡蓝绿色的上清。随着培养时间的延长,这种淡蓝绿色的液体渐渐增多,色也变深。打开试管塞,可嗅到一种芳香气味。
普通琼脂培养基
37℃培养18-24h,形成光滑、微隆起、边缘整齐或波状的中等大小菌落。由于水热溶性绿脓素(蓝绿色)和荧光素(黄绿色),渗入培养基内,可使培养基呈黄绿色,并具有独特气味(生姜味或烂苹果味)。数日后,培养基的绿色逐渐变深,菌落表面呈现金属光泽。
血液琼脂
37℃培养18-24h,生长成扁平、湿润、边缘不整的菌落,常易融合成菌苔。置室温暗处逐渐出现蓝绿色金属光泽。因其能产生绿脓酶,溶解红细胞,故在菌落周围会出现轻度溶血环。
SS琼脂
37℃培养18-24h,生长受到抑制,可形成无色半透明小菌落,如培养稍久后,菌落中央呈绿棕色,易与肠道致病菌混淆,观察时应加以注意。
麦康凯琼脂
37℃培养24h,生长良好,培养基呈淡暗绿色,菌落不变红。
三糖铁培养基
37℃培养18-24h,不产生硫化氢,底部不变黄。
Cetrimide琼脂
多用于分离和鉴定病料污染严重的铜绿假单胞菌(荧光假单胞菌亦能生长),菌落扁平无定型,向周边扩散或略有蔓延趋势,菌落呈灰白色,周围有水溶性色素,而其他各种假单胞菌及有关的非发酵型细菌均被抑制。
注:①铜绿假单胞菌及蓝色荧光杆菌多种培养物在紫外光照射条件下可发出黄绿色及蓝色荧光;
②初次分离的铜绿假单胞菌可能有不产生色素、无动力的变异菌株,需在普通琼脂上和肉汤中传代,若出现色素、恢复动力,即可判断为铜绿假单胞菌。